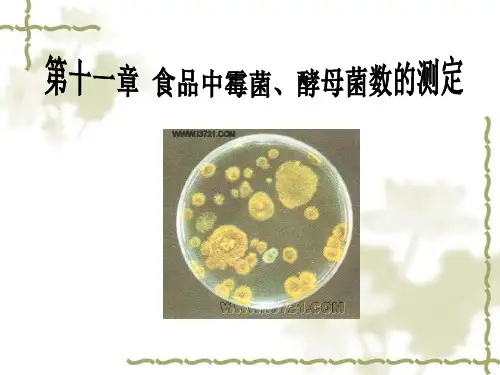
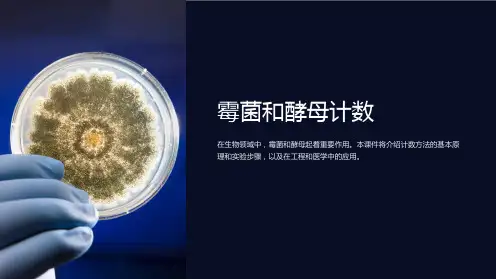

霉菌和酵母菌介绍及检测方法之令狐文艳创作
- 格式:doc
- 大小:17.51 KB
- 文档页数:5


霉菌、酵母菌检验(一)实验原理霉菌和酵母菌菌数的测定是指食品检样经过处理,在一定条件下培养后,所得1g 或1mL检样中所含的霉菌和酵母菌菌落数(粮食样品是指1g粮食表面的霉菌总数)。
(二)实验器材1.培养基:马铃薯-葡萄糖-琼脂培养基马铃薯(去皮切块)300 g葡萄糖20.0 g琼脂20.0 g氯霉素0.1 g蒸馏水1000 mL制法:将马铃薯去皮切块,加1000mL蒸馏水,煮沸10 min-20 min。
用纱布过滤,补加蒸馏水至1000 mL。
加入葡萄糖和琼脂,加热溶化,分装后,121 ℃灭菌20 min。
倾注平板前,用少量乙醇溶解氯霉素加入培养基中。
2.器皿:已灭菌的平皿(9套/组),1mL吸管(6支/组),试管(15×150)(6/组),三角锥瓶500mL、三角锥瓶500mL(内装蒸馏水250mL),10mL吸管。
3.其他:牛皮纸或报纸,酒精灯,棉花,高压蒸汽菌锅,电烘箱,线绳,毛刷等。
(三)操作步骤1.检验程序2.操作要点1)采样选取有代表性的样品并避免采样时的污染。
2)样品处理(1)以无菌操作称取检样25mL,放入含有225mL灭菌水的玻塞三角瓶中,振摇30 min,即为1:10稀释液。
(2)用灭菌吸量管吸取1:10稀释液10mL,注入试管中,另用带橡皮乳头的1mL 灭菌吸量管反复吹吸50次,使霉菌孢子充分散开。
(3)取1mL 1:10稀释液注入含有9mL灭菌水的试管中,另换一支1mL灭菌吸量管吹吸5次,此液为1:100稀释液。
(4)按上述操作顺序做10倍递增稀释液,每稀释一次,换用一支1mL灭菌吸量管。
3)接种培养根据对样品污染情况的估计,选择3个合适的稀释度,分别在做10倍稀释的同时,吸取1mL稀释液于灭菌平皿中,每个稀释度做2个平皿,然后将凉至45 ℃左右的培养基注入平皿中,待琼脂凝固后,倒置于25-28℃温箱中,3d后开始观察,共培养观察5d。
4)计算方法通常选择菌落数在10-150之间的平皿进行计数,一个稀释度使用两个平板,采用两个平板的平均数;选择稀释度也选择平均菌落数在10-150之间的稀释度,菌落平均数乘以稀释倍数,即为每克(或毫升)检样中所含霉菌和酵母数。

作业指导书版本号: A修改号: 0 标题:霉菌和酵母菌的测定页码: 1/2使用部门中心化验室编制审核批准日期日期日期检验目的和范围:对一定数量的样品或在无菌操作条件下获得的样品稀释液进行霉菌和酵母数的测定。
操作程序:1.0样品准备1.1样品编号:运用相应的标记,对样品进行编号,并记录在“微生物检验原始记录表中。
1.2样品稀释1.2.1样品稀释度的选择1.2.1.1固体样品选取10-1至10-2两个稀释度的样品稀释液。
1.2.1.2液体样品1.2.1.2.1常规产品检验选取原样。
1.2.1.2.2中间产品检验选取10-1至10-2两个稀释度的样品稀释液。
1.2.1.2.3问题产品检验根据样液污染情况,选取二至三个稀释度的样品稀释液。
1.2.2样品稀释方法1.2.2.1以无菌操作称取样品25g(或25mL),放入含有225mL灭菌生理盐水的玻塞三角瓶中,振摇30min,即为1:10稀释液。
1.2.2.2 用灭菌吸管吸取1:10稀释液10mL,注入试管中,另用带橡皮乳头的1mL灭菌吸管反复吹吸50次,使霉菌孢子充分散开。
1.2.2.3取1mL注入含有9mL灭菌生理盐水的试管中,另换一支1mL灭菌吸管吹吸5次,此液为1:100稀释液。
1.2.2.4按上条操作顺序,做10倍递增稀释液。
2.0培养基配备2.1按照生物试剂培养基的使用方法配制虎红琼脂培养基,并在46±1℃恒温或水浴中保温待用。
3.0接种培养3.1按样品编号在灭菌平皿底部作相应标记。
作业指导书版本号: A修改号: 0 标题:霉菌和酵母菌的测定页码: 2/23.2在两个灭菌平皿内倾入15mL虎红琼脂培养基,其中一个平皿作为培养基空白对照样品,另一个暴露至接种过程结束,作为实验环境对照样品。
3.3用1mL的灭菌吸管或注射器移取1mL选定的样品稀释液或样品原样至灭菌平皿内,每个样品做两个平皿。
3.4 按以上步骤,以1mL无菌生理盐水作为空白操作对照。

酵母菌的检测方法嘿,你问酵母菌的检测方法啊?这事儿还挺有门道呢。
咱先说说一种比较简单的方法吧,那就是观察法。
你可以找一些可能含有酵母菌的东西,比如面团啊、水果啊啥的。
把它们放在一个干净的地方,然后仔细观察。
如果过了一段时间,你看到这些东西上面出现了一些小气泡,或者变得有点松软,那很可能就有酵母菌在里面活动呢。
就好像酵母菌是一群小调皮,在那里捣乱,弄出了这些动静。
还有一种方法是显微镜观察法。
这就需要用到显微镜啦。
你可以从那些可能有酵母菌的东西上取一点样本,放在显微镜下观察。
如果看到一些小小的、圆圆的东西,那可能就是酵母菌啦。
酵母菌在显微镜下就像一个个小气球,可有意思啦。
不过用显微镜的时候要小心哦,别把样本弄得到处都是,也别把显微镜给弄坏了。
另外呢,还有一种培养法。
就是把可能含有酵母菌的样本放在一个适合酵母菌生长的环境里,看看会不会长出酵母菌来。
比如说,可以用一些专门的培养基,把样本涂在上面,然后放在温暖的地方。
如果过了几天,培养基上出现了一些白色的或者黄色的斑点,那很可能就是酵母菌长出来啦。
这就像给酵母菌盖了一个小房子,让它们在里面舒舒服服地长大。
总之呢,检测酵母菌有各种方法。
你可以根据自己的情况选择合适的方法。
要是你只是好奇想看看有没有酵母菌,那就用观察法试试。
要是你想看得更清楚,那就用显微镜观察法。
要是你想确定到底有没有酵母菌,那就用培养法。
不管用哪种方法,都能让你找到酵母菌这个小调皮哦。

物理消毒灭菌法(一)令狐文艳(二)物理消毒灭菌法1.热力消毒灭菌法:利用热力作用破坏微生物的蛋白质、核酸、细胞壁、细胞膜,导致其死亡,可分为干热法和湿热法。
(1)燃烧法:属于干热法,是一种简单、迅速、彻底的灭菌方法。
1)用途:①无保留价值的污染物品②金属器械及搪瓷类物品急用,或无条件消毒时,锐利刀剪除外,以免锋刃变钝。
2)方法:①金属器械可在火焰上烧20秒②搪瓷类容器可倒入少量95%乙醇(2)干烤法:利用特制的烤箱,热力通过空气对流和介质传导进行灭菌,效果可靠。
(3)煮沸消毒法:属于湿热法,用于耐湿、耐高温的搪瓷、金属、玻璃,橡胶类物品,不能用于外科手术器械的灭菌。
从水煮开始计时,5-10分钟可杀灭繁殖体,15分钟可将多数细菌芽胞杀灭,如破伤风杆菌芽胞需煮60分钟才可杀灭,在水中加入碳酸氢钠,配成浓度为1%-2%的溶液时,沸点可达105度,即可增强杀菌作用,又可去除防锈。
注意事项:①物品需全部侵入在水中,物品盖子打开,轴节打开,空腔导管预先灌水,各种大小及形状相同的容器不能重叠②玻璃类物品需用纱布包裹,并在冷水或温水中放入③橡胶类物品需用纱布包好,水沸后放入④如中途加入其它物品,需等再次水沸后开始计时⑤高原地区气压低,沸点低,需适当延长煮沸时间,一般海拔每增高300m,煮沸时间延长2分钟。
(4)压力蒸汽灭菌法:属于湿热法,是一种临床上应用最广泛,效果最为可靠的首选灭菌方法2.光照消毒法(又称辐射消毒)主要是通过紫外线的杀菌作用,使菌体蛋白发生光解、变性,导致细菌死亡。
(1)日光暴晒法:利用日光的热、干燥、紫外线的作用来杀菌,将床垫、毛毯、书籍、衣服等放在阳光下直射,暴晒6小时可达到消毒效果,中间要定时翻动。
(2)紫外线灯管消毒法:紫外线属于电磁波辐射,常用于空气、物品表面的消毒,杀菌最强的波长范围250-270nm从灯亮5-7分钟开始计时。
①空气消毒:有效距离不超过2m,照射时间20-30分钟②物品消毒:有效距离不超过25-60cm,照射时间20-30分钟。
霉菌和酵母菌介绍及检测方法
令狐文艳
一、霉菌和酵母菌介绍:
霉菌和酵母菌及其检验酵母菌是真菌中的一大类,通常是单细胞,呈圆形,卵圆形、腊肠形或杆状。
霉菌也是真菌,能够形成疏松的绒毛状的菌丝体的真菌称为霉菌。
霉菌和酵母广泛分布于自然界并可作为食品中正常菌相的一部分。
长期以来,人们利用某些霉菌和酵母加工一些食品,如用霉菌加工干酪和肉,使其味道鲜美;还可利用霉菌和酵母酿酒、制酱;食品、化学、医药等工业都少不了霉菌和酵母。
但在某些情况下,霉菌和酵母也可造成中腐败变质。
由于它们生长缓慢和竞争能力不强,故常常在不适于细菌生长的食品中出现,这些食品是pH低、湿度低、含盐和含糖高的食品、低温贮藏的食品,含有抗菌素的食品等。
由于霉菌和酵母能抵抗热、冷冻,以及抗菌素和辐照等贮藏及保藏技术,它们能转换某些不利于细菌的物质,而促进致病细菌的生长;有些霉菌能够合成有毒代谢产物-霉菌毒素。
霉菌和酵母往往使食品表面失去色、香、味。
例如,酵母在新鲜的和加工的食品中繁殖,可使食品发生难闻的异味,它还可以使液体发生混浊,产生气泡,形成薄膜,改变颜色及散发不正常的气味等。
因此霉菌和酵母也作为评价食品卫生质量的指示菌,并以霉菌和酵母计数来制定食品被污染的程度。
目前已有若干个国家制订了
某些食品的霉菌和酵母限量标准。
我国已制订了一些食品中霉菌和酵母的限量标准。
二、检验方法:
霉菌和酵母的计数方法,与菌落总数的测定方法基本相似。
主要步骤为:将样品制作成10倍梯度的稀释液,选择3个合适的稀释度,吸取1mL于平皿,倾注培养基后,培养观察,计数。
对霉菌的计数,还可以采用显微镜直接镜检计数的方法。
具体检测标准参见:
GB4789.15-94,《中华人民共和国国家标准食品卫生微生物检验霉菌和酵母计数》
三、说明:
1.样品的处理。
为了准确测定霉菌和酵母数,真实反映被检食品的卫生质量,首先应注意样品的代表性。
对大的固体食品样品,要用灭菌刀或镊子从不同部位采取试验材料,再混合磨碎。
如样品不太大,最好把全部样品放到灭菌均质器杯内搅拌2min。
液体或半固体样品可用迅速颠倒容器25次来混匀。
2.样品的稀释:为了减少榈稀释倍数的误差,在连续递增稀释时,每一稀释度应更换一根吸管。
在稀释过程中,为了使霉菌的孢子充分散开,需用灭菌吸管反复吹吸50次。
3.培养基的选择:在霉菌和酵母计数中,主要使用以下几种选择性培养基。
马铃薯-葡萄糖-琼脂培养基(PDA):霉菌和酵母在PDA培养基上生长良好。
用PDA作平板计数时,必项加入抗菌素以抑制细菌。
孟加拉红(虎红)培养基:该培养基中的孟加拉红和抗菌素具有抑制细菌的作用。
孟加拉红还可抑制霉菌菌落的蔓延生长。
在菌落背面由孟加拉红产生的红色有助于霉菌和酵母菌落的计数。
高盐察氏培养基:粮食和食品中常见的曲霉和青霉在该培养基上分离效果良好,它具有抑制细菌和减缓生长速度快的毛霉科菌种的作用。
4.倾注培养。
每个样品应选择3个适宜的稀释度,每个稀释度倾注2个平皿。
培养基熔化后冷却至45℃,立即倾注并旋转混匀,先向一个方向旋转,再转向相反方向,充分混合均匀。
培养基凝固后,把平皿翻过来放温箱培养。
大多数霉菌和酵母在25-30℃的情况下生长良好,因此培养温度25~28℃。
培养3d后开始观察菌落生长情况,共培养5d观察记录结果。
5.菌落计数及报告:选取菌落数10~150之间的平板进行计数。
一个稀释度使用两个平板,取两个平板菌落数的平均值,乘以稀释倍数报告。
固体检样以g为单位报告,液体检样以mL 单位报告。
关于稀释倍数的选择可参考细菌菌落总数测定。
6.霉菌直接镜检计数法:对霉菌计数,可以采用直接镜检
的方法进行计数。
在显微镜下,霉菌菌丝具有如下特征:
平行壁:霉菌菌丝呈管状,多数情况下,整个菌丝的直径是一致的。
因此在显微镜下菌丝壁看起来象两条平行的线。
这是区别霉菌菌丝和其他纤维时最有用的特征之一。
横隔:许多霉菌的菌丝具有横隔,毛霉、根霉等少数霉菌的菌丝没有横隔。
菌丝内呈粒状:薄壁、呈管状的菌丝含有原生质,在高倍显微镜下透过细胞壁可见其呈粒状或点状。
分枝:如菌丝不太短,则多数呈分枝状,分枝与主干的直径几乎相同,有分枝是鉴定霉功得出可靠的特征之一。
菌丝的顶端:常呈钝圆形。
无折射现象。
凡有以上特征之一的丝状均可判定为霉菌菌丝。
观察视野中有无菌丝,凡符合下列情况之一者为阳性视野。
一根菌丝长度超过视野直径1/6;
一根菌丝长度加上分枝的长度超过视野直径1/6;
两根菌丝总长度超过视野直径1/6;
三根菌丝总长度超过视野直径1/6;
一丛菌丝可视为一个菌丝,所有菌丝(包括分枝)总长度超过视野直径1/6。
根据对所有视野的观察结果,计算阳性视野所占比例,并以阳性视野百分数(%)报告结果。
计算公式:
每件样品阳性视野(%)=(阳性视野数 / 观察视野数)×100。